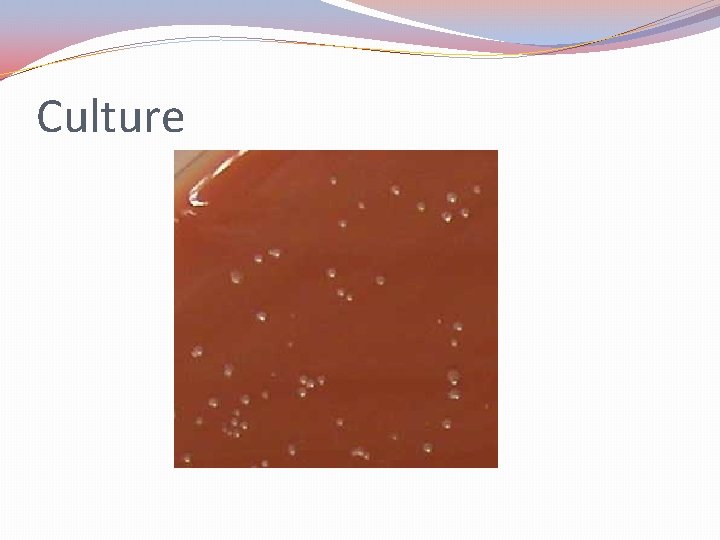
Culture
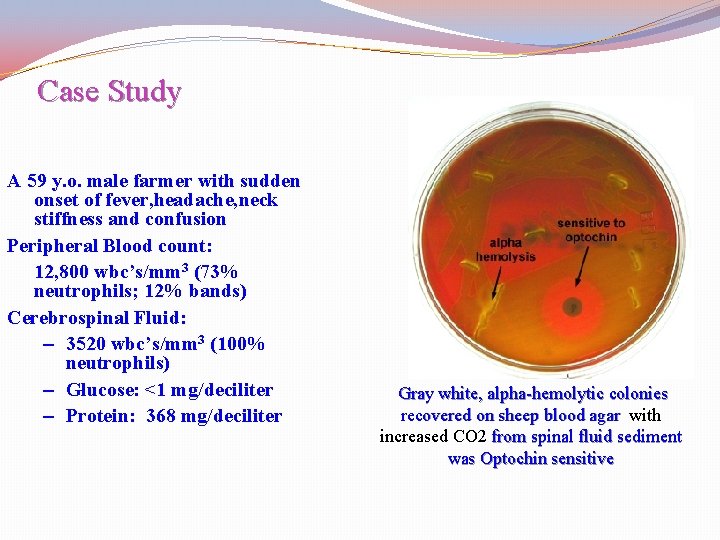
Case Study A 59 y. o. male farmer with sudden onset of fever, headache,
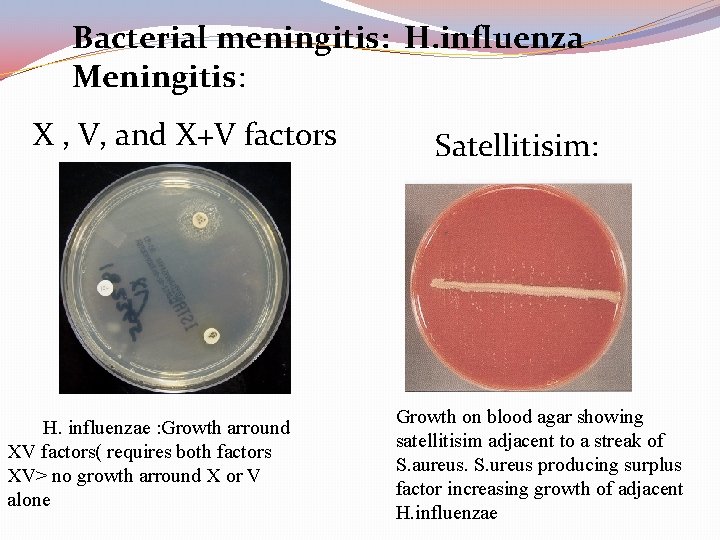
Bacterial meningitis: H. influenza Meningitis: X , V, and X+V factors H. influenzae :
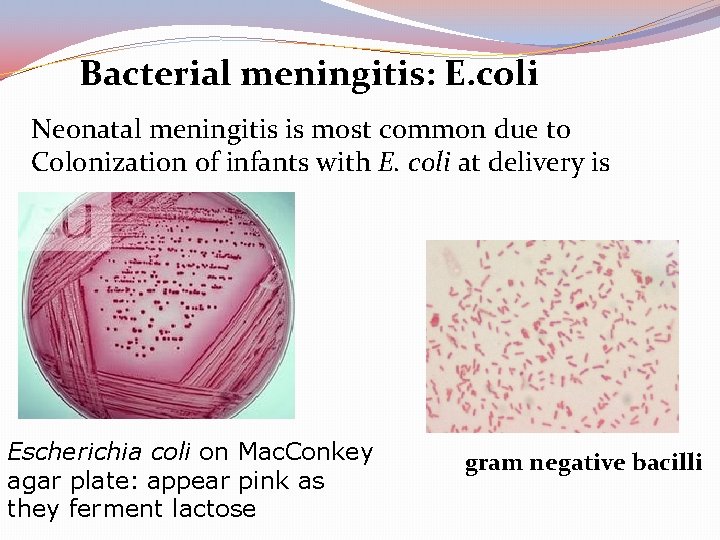
Bacterial meningitis: E. coli Neonatal meningitis is most common due to Colonization of infants

Integrated Practical Class YEAR TWO NERVOUS SYSTEM BLOCK

Integrated Practical Class YEAR TWO, NERVOUS SYSTEM BLOCK STUDENT ‘S TASK WEEK 7

This integrated Practical class is designed by: �Professor Samy A. Azer (Department of Medical Education) �Dr. Rana Hasanato (Clinical Biochemistry Unit) �Dr. Ali Somily (Microbiology Unit) Copyright Statement This material is protected by copyright laws. For any other purposes other than teaching and research in the King Saud University, no part may be reproduced or copied in any form or by means without prior permission of the King Saud University. © King Saud University, Kingdom of Saudi Arabia (2010).

This integrated Practical class: NERVOUS SYSTEM BLOCK (WEEK 7) �ORGANIZATION OF THE PRACTICAL CLASS: This practical class is for 2 hours. Students are divided into two equal groups as per information provided earlier (Group A and Group B). The class has two main components, each is about 60 minutes long.

COMPONENT ONE Group A will start by completing component one of the practical class. The venue for this component is the Third Floor, College Building, Pharmacology Lab. This component comprises three cases at a time. The time allocated for each case is 12 minutes. Each case will be followed by a tutor discussion and model answer (5 minutes). The tutors will then guide you to move to the next case. At the end of this component, the turtor will guide you to do component two of the practical class.

COMPONENT TWO Group B will start by completing component two of the practical class. The venue for this component is the Second Level, College Building, Multipurpose Lab. This component comprises a 10 minute video on Lab Safety procedures. The hands -on training practical component for about 40 minutes. At the end of this component, the tutor will guide you to do component one of the practical class.

All students after completing both components of the practical class have to complete a questionnaire (10 minutes). The attendance of the practical will be taken at the end of the practical and after completing the questionnaire.

CASE 1 (20 MINUTES) It is about one week after the Hajj time, Mr. Mohammed Khan, a Pakistan citizen has completed the Hajj holy duty and is preparing to go home. A day before his travel he present to the emergency department (A & E) at Al Noor Hospital in Makkah because of headache, vomiting and high temperature. On clinical examination he has a rash on his body, (see the picture provided). Mr. Khan’s relatives who has brought him to the Hospital mentions that Mr. Kahan received vaccination required for Hajj, a day before his travel for Hajj. The doctor in the emergency department takes a detailed history and conducts a clinical examination. Because of clinical findings, he decided to do lumber puncture. The result of the lumber puncture are shown in the next slide.


The characteristic skin rash (purpura) of meningococcal septicemia, caused by Neisseria meningitidis

Normal and turbid CSF

CSF Patient’s Result Normal Range Appearance Turbid Clear WBC and differential Few (<5 cells/mm 3) Protein 1400 per mm 3 Mainly polymorphnuclear leucocytes (80%) 5. 0 Glucose 1. 3 3. 0 -4. 5 mmol/L chloride 110 115 -130 mmol/L 0. 1 -0. 4 g/L

QUESTION 1: What is your diagnosis? ………………………………………………………… QUESTION 2: What is the most likely infection responsible? (Select only one) q. Mycobacterium Avium q. Fungal infection q. Parasitic infection q. Viral infection q. Bacterial infection q. Trepanoma pallidum (Neurosyphilis) q. Mycobacterium tuberculosis

QUESTION 3: What is your justification for your answer to question two? ………………………………………………………… QUESTION 4: What further investigation would you like to do at this stage? ………………………………………………………… QUESTION 5: Mr. Khan has received the required vaccination before his travel, how would you explain his infection despite vaccination? …………………………………………………………

Gram Stain
Culture

CASE 2 (20 MINUTES) A 10 -year old boy is brought to the emergency department (A&E) at King Khalid Hospital accompanied by his mother. He has fever, headache, and vomiting for the last 2 days. Clinical examination confirmed that he has meningeal irritation. The doctor decided to do a lumber puncture.

CSF Patient’s Result Normal Range Appearance Clear WBC and differential 1200 per mm 3 Mainly lymphocytes (80%) Few (<5 cells/mm 3) Protein 0. 5 0. 1 -0. 4 g/L Glucose 2. 7 3. 0 -4. 5 mmol/L chloride 100 115 -130 mmol/L

QUESTION 1: What is your most likely diagnosis? ………………………………………………………… QUESTION 2: What is the most likely infection responsible? (Select only one) q. Mycobacterium Avium q. Fungal infection q. Parasitic infection q. Viral infection q. Bacterial infection q. Trepanoma pallidum (Neurosyphilis) q. Mycobacterium tuberculosis

QUESTION 3: What is your justification for your answer to question two? ……………………………………………… QUESTION 4: What further investigation would you like to do at this stage? ………………………………………………

Bacterial meningitis: Pneumococcal Meningitis Direct gram stain of a CSF deposit shows gram-positive diplococcic with lanceolate shape and polymorphneoclear leucocytes
Case Study A 59 y. o. male farmer with sudden onset of fever, headache, neck stiffness and confusion Peripheral Blood count: 12, 800 wbc’s/mm 3 (73% neutrophils; 12% bands) Cerebrospinal Fluid: – 3520 wbc’s/mm 3 (100% neutrophils) – Glucose: <1 mg/deciliter – Protein: 368 mg/deciliter Gray white, alpha-hemolytic colonies recovered on sheep blood agar with increased CO 2 from spinal fluid sediment was Optochin sensitive


Bacterial meningitis: Hinfluenza Meningitis: is caused mainly by hemophilus influenzae type b Gram negative coccobacilli Requires X & V growth factors for growth The optimum growth temperature is 35°C - 37°C in 5% CO 2

Gram stain : CSF Deposit Culture: H. influenzae on chocolate agar Gram-Negative coccobacilli with many polymorphneuclear leucocyte Grow well on chocolate agar at 35°C - 37°C in 5% CO 2, colonies are convex, smooth, pale, grey or transparent
Bacterial meningitis: H. influenza Meningitis: X , V, and X+V factors H. influenzae : Growth arround XV factors( requires both factors XV> no growth arround X or V alone Satellitisim: Growth on blood agar showing satellitisim adjacent to a streak of S. aureus. S. ureus producing surplus factor increasing growth of adjacent H. influenzae
Bacterial meningitis: E. coli Neonatal meningitis is most common due to Colonization of infants with E. coli at delivery is Escherichia coli on Mac. Conkey agar plate: appear pink as they ferment lactose gram negative bacilli

Microbiological Finding CSF Molecular testing is positive for Herpes simplex � type II

CASE 3 (20 MINUTES) A 65 -year-old is referred from a general practitioner because of headache, fever, excessive sweating at night, and weight loss over the last 4 -5 months. He has lost his appetite for food. On examination, there is neck rigidity. Laboratory tests including blood count, serum and electrolytes, blood urea, creatinine and blood culture all normal. The doctors decides to do a lumber puncture. The results of the lumber puncture are shown in the next slide:

CSF Patient’s Result Normal Range Appearance Turbid Clear WBC and differential 300 per mm 3 Mainly lymphocytes Few (<5 cells/mm 3) Protein 0. 8 0. 1 -0. 4 g/L Glucose 2. 0 3. 0 -4. 5 mmol/L chloride 115 -130 mmol/L

QUESTION 1: What is your most likely diagnosis? …………………………………………………… QUESTION 2: What is the most likely infection responsible? (Select only one) q. Fungal infection q. Parasitic infection q. Viral infection q. Bacterial infection q. Trepanoma pallidum (Neurosyphilis) q. Mycobacterium tuberculosis

QUESTION 3: What is your justification for your answer to question two? ……………………………………………… QUESTION 4: What further investigation would you like to do at this stage? (State 3) ………………………………………………

Acid Fast Smear and TB Culture
- Slides: 32